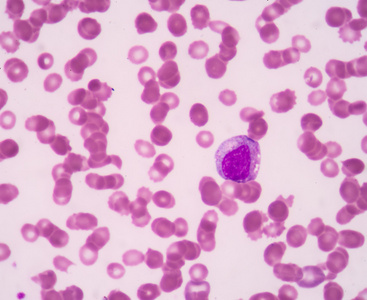
早幼粒细胞照片
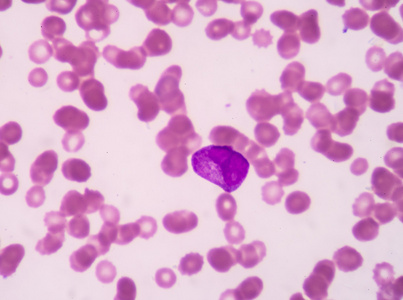
早幼粒细胞照片

早幼粒

早幼粒细胞 03
图片尺寸650x484
早幼粒细胞
图片尺寸1080x810
实验诊断学 早幼粒细胞
图片尺寸1080x810
实验诊断学 早幼粒细胞 ↓ ↑ 中幼红细胞
图片尺寸1080x810
图12 肺片型的早幼粒细胞(2)关于早期识别m3的要点中,有老师提及血
图片尺寸772x663
【原创】正常早幼粒和异常早幼粒细胞区别
图片尺寸639x772
体检中心健康体检发现急性早幼粒细胞白血病一例
图片尺寸1600x1200
急性早幼粒细胞白血病的流行病学
图片尺寸300x225
早幼粒细胞
图片尺寸640x480
早幼粒细胞照片
图片尺寸410x300
早幼粒细胞图片
图片尺寸546x480
早幼粒细胞照片
图片尺寸367x300
原始粒细胞早幼粒细胞中幼粒细胞晚幼粒细胞成熟粒细胞
图片尺寸1080x1139
一例急性早幼粒细胞白血病
图片尺寸1080x1441
医学检验异常早幼粒细胞366
图片尺寸1080x1439
早幼粒细胞
图片尺寸1200x803
特异性颗粒,可以划分为中性中幼粒,嗜酸性中幼粒,嗜碱性中幼粒早幼粒
图片尺寸1080x566
早幼粒细胞照片
图片尺寸403x300
(图) 早幼粒细胞
图片尺寸1111x880
早幼粒细胞
图片尺寸461x437